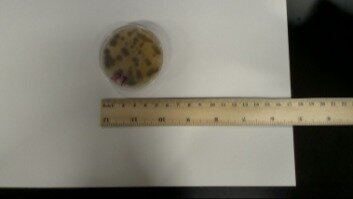

Clean Our School's Water Fountains
The Issue
As a concerned student, I've noticed an alarming issue that affects all students on a daily basis. Our school's water fountains are a breeding ground for bacteria and dirt, which leads to a serious health risk to everyone who uses them. It's disheartening that in a place meant for learning and growth, we're faced with unsafe options for something as basic and essential as drinking water. The picture above shows a the water fountain bacteria after we collected a sample and allowed the bacteria to be visible. Specifically in the nozzle and surrounding area where the water is dispensed. This is the water students like yourself or your children must drink to survive the seven hour school days.
The Centers for Disease Control and Prevention (CDC) states the upmost importance of having access to clean and safe drinking water, especially in schools where hydration is key for student concentration and performance. Regardless, our fountains remain neglected, evident through discoloration, unpleasant odors, and visible dirt and bacteria. This issue must be addressed immediately to prevent illness and ensure the well-being of all students.
Regular cleaning and maintenance schedules should be established, with clear guidelines for hygiene standards. Schools should move resources for checks to ensure cleanliness and functionality. Installing better filtration in fountains can also significantly improve water quality. Even pooling funding for a bi or tri yearly replacement of water fountains over the course of the break period can save countless students.
As a student, the educational journey can be stressful, hard and energy consuming. Therefore students need to stay hydrated during these hours to maintain proper mental capacity and meet physical standards. Our water fountains aren't sufficient enough for this previous claim, which leads to our current procedures. Our school chills the "water" to numb the taste buds of students drinking the supposed hydrating liquid, this is evident as through spring, fall, and even winter the water fountains in our facility remain chilled. Though... it can't be masked forever, sights and claims from various students across the campus have reported drinking from a water fountain when the water isn't warm and have reported an odor as well as a metallic and bitter taste most even spitting it out to find another fountain.
The school district is aware and taking advantage of this situation by implementing MISD branded water bottles able for purchase at the "low price of 1.75$" and students who can't afford this water during the school day are forced to bring their own or drink from the unsanitary fountains. Staff and more are also aware of this as a large majority of custodians, staff, and teachers at the facility bring their own water at home aware of the conditions.
The Law states federal law in the United States, specifically the Healthy, Hunger-Free Kids Act of 2010, requires schools participating in the National School Lunch Program to make free, potable (safe) water available to students. We are in direct violation of this law and need to change our quality to abide by these laws. This is a federal crime to deny kids from safe, clean, and free water within the school day.
By signing this petition, you are advocating for a healthier and safer learning environment for students. Your support can drive necessary action from school administrations and local governments to prioritize students' health and well-being. Join us in making sure that all school water fountains are cleaned and properly maintained so that every student can stay hydrated without fear of contamination. Please sign this petition now to make a difference.
65
The Issue
As a concerned student, I've noticed an alarming issue that affects all students on a daily basis. Our school's water fountains are a breeding ground for bacteria and dirt, which leads to a serious health risk to everyone who uses them. It's disheartening that in a place meant for learning and growth, we're faced with unsafe options for something as basic and essential as drinking water. The picture above shows a the water fountain bacteria after we collected a sample and allowed the bacteria to be visible. Specifically in the nozzle and surrounding area where the water is dispensed. This is the water students like yourself or your children must drink to survive the seven hour school days.
The Centers for Disease Control and Prevention (CDC) states the upmost importance of having access to clean and safe drinking water, especially in schools where hydration is key for student concentration and performance. Regardless, our fountains remain neglected, evident through discoloration, unpleasant odors, and visible dirt and bacteria. This issue must be addressed immediately to prevent illness and ensure the well-being of all students.
Regular cleaning and maintenance schedules should be established, with clear guidelines for hygiene standards. Schools should move resources for checks to ensure cleanliness and functionality. Installing better filtration in fountains can also significantly improve water quality. Even pooling funding for a bi or tri yearly replacement of water fountains over the course of the break period can save countless students.
As a student, the educational journey can be stressful, hard and energy consuming. Therefore students need to stay hydrated during these hours to maintain proper mental capacity and meet physical standards. Our water fountains aren't sufficient enough for this previous claim, which leads to our current procedures. Our school chills the "water" to numb the taste buds of students drinking the supposed hydrating liquid, this is evident as through spring, fall, and even winter the water fountains in our facility remain chilled. Though... it can't be masked forever, sights and claims from various students across the campus have reported drinking from a water fountain when the water isn't warm and have reported an odor as well as a metallic and bitter taste most even spitting it out to find another fountain.
The school district is aware and taking advantage of this situation by implementing MISD branded water bottles able for purchase at the "low price of 1.75$" and students who can't afford this water during the school day are forced to bring their own or drink from the unsanitary fountains. Staff and more are also aware of this as a large majority of custodians, staff, and teachers at the facility bring their own water at home aware of the conditions.
The Law states federal law in the United States, specifically the Healthy, Hunger-Free Kids Act of 2010, requires schools participating in the National School Lunch Program to make free, potable (safe) water available to students. We are in direct violation of this law and need to change our quality to abide by these laws. This is a federal crime to deny kids from safe, clean, and free water within the school day.
By signing this petition, you are advocating for a healthier and safer learning environment for students. Your support can drive necessary action from school administrations and local governments to prioritize students' health and well-being. Join us in making sure that all school water fountains are cleaned and properly maintained so that every student can stay hydrated without fear of contamination. Please sign this petition now to make a difference.
The Decision Makers


Supporter Voices
Petition Updates
Share this petition
Petition created on February 26, 2026